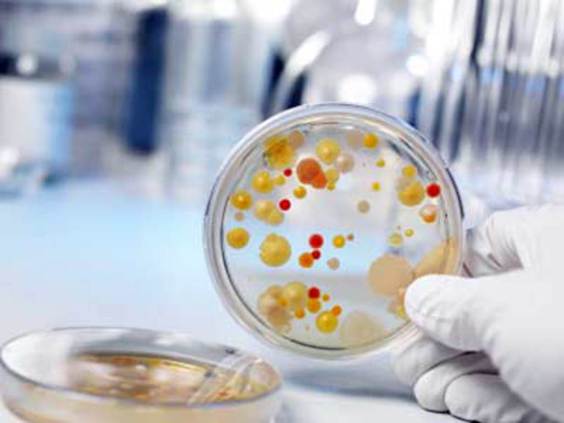
Гарднерелла.jpg

Гарднерелла (Gardnerella vaginalis) - возбудитель бактериальной инфекции - гарднереллеза, воспалительного заболевания мочеполового тракта.
Гарднерелла (Gardnerella vaginalis) - возбудитель бактериальной инфекции - гарднереллеза, воспалительного заболевания мочеполового тракта.
Впервые гарднереллу описали в середине двадцатого века. Она имеет типичное для прокариот строение, но по размеру немного крупнее гонококка. Если посмотреть на материалы для исследования, которые взяты у больных гарднереллезом, то можно увидеть, что клетки эпителия половой системы покрыты клетками возбудителя. Вызывая воспаления урогенитального тракта, данная инфекция может привести к тяжелым последствием, например, к бесплодию.
Следует отметить, что она присутствует в микрофлоре мочеполового тракта здоровых людей, только в очень маленьких количествах. По мнению некоторых ученых, сама бактерия не является возбудителем инфекционного заболевания, но она создает благоприятные условия других микроорганизмов и анаэробных бактерий.
Бактерии размножаются в микрофлоре влагалища и уретры, при этом продукты их жизнедеятельности достаточно быстро разрушают нормальную микрофлору мочеполового тракта. Относясь к анаэробным бактериям, гарднерелла способна размножаться в обедненной кислородом среде, способствуя развитию воспалительных процессов, в которых могут участвовать и другие микроорганизмы.
Диагностика ПЦР, культуральный метод
Без соответствующего лечения инфекция восходящим путем может попасть из уретры в матку и фаллопиевы трубы. Нередко данная инфекция служит причиной вагинитов.
Имеются противопоказания. Ознакомьтесь с инструкцией или проконсультируйтесь у специалиста.
